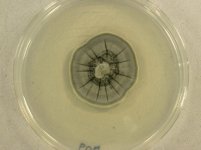

<< back to search
IMAGES:







Search Details
add to cart
| UAMH Number: | 11271 |
|---|---|
| Species Name: | Hyaloscypha variabilis |
| Type: | |
| Synonyms: | Meliniomyces variabilis |
| Taxonomy: | FUNGI Ascomycota, Leotiomycetes, Helotiales, Hyaloscyphaceae |
| Strain History: | Grelet, G.A. (GT3V3) -> UAMH |
| Substrate: | Vaccinium hair root adjacent to P. bicolorata ectomycorrhizal pine root tip, in soil core 0-12 cm deep | Location: | UNITED KINGDOM Scotland, Aberdeenshire, Aboyne, Glen Tanar semi-natural Scots Pine Forest (GEO: 57.055,-2.843) |
| Isolator: | G.A. Grelet (Var94) |
| Isolation Date: | 2006 |
| Date Received: | 2010-09-13 |
| Characters: | MYCORRHIZAE co-colonization of ectomycorrhizal and ericoid roots - Grelet GA, Johnson D, Vrålstad T, Alexander IJ, Anderson IC, New Phytologist 188:210-222, 2010 (Click for publications citing UAMH 11271) |
| Compounds: | |
| Cross Reference: | |
| Collections: | Living Strains; Dried Herbarium Material |
| Pathogenic Potential: | Human: no | Animal: no | Plant: yes |
| Biosafety Risk Group: | RG1 (check the PHAC ePATHogen Risk Group Database for updates) |
| Regulatory Requirements: | Canadian requesters must provide PHAC Pathogen and Toxin License Number (see: https://www.canada.ca/en/public-health/services/laboratory-biosafety-biosecurity/licensing-program.html) prior to shipment. International requesters must provide all legally required importation documentation prior to shipment. Plant pathogenicity status may be verified by using the USDA Agricultural Research Service (ARS) Fungal Database |
| MycoBank ID: | 825018 |
| Sequences: | >UAMH11271_FN678860_SSU-LSU CATTAAAGAAAGAGAAACGTCCCGTTTTTTTTCATAAGAATGGGTTCTATTCCCTTAAACCGTGTCTACATACCTTTGTTGCTTTGGCAGGCCGCCTTCGGGCGTCGGCTCCGGCTGATAGTGCCTGCCAGAGGACCCAAACTCTATGTTTAGTGATGTCTGAGTACTATATAATATTTAAAACTTTCAACAACGGATCTCTTGGTTCTGGCATCGATGAAGAACGCAGCGAAATGCGATAAGTAATGTGAATTGCAGAATTCAGTGAATCATCGAATCTTTGAACGCACATTGCGCCCCTTGGTATTCCGAGGGGCATGCCTGTTCGAGCGTCATTATAACCACTCAAGCCTGGCTTGGTATTGGGGTTTTCGCGTGTTCGCGGCCCTTAAAATCAGTGGCGGTGCCGTCTGGCTCTAAGCGTAGTAATTTCTCTCGCTATAGGGTTCCGGTGGTTACTTGCCAAAACCCCCCATTTTTTCTAGGTTGA |
IMAGES: